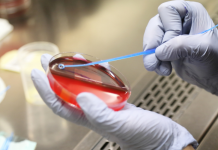
Anti Tübüler Bazal Membran Nefriti Nedir?

Böbrek yetmezliği nedir?
Böbrekleriniz, belinize doğru yerleştirilmiş bir çift organdır. Bir böbrek, omurganızın her iki tarafında. Kanınızı filtreler ve vücudunuzdaki toksinleri temizler. Böbrekleriniz mesanenize toksinler gönderir. Vücudunuz daha sonra idrar yaparken toksinleri çıkarır.
Böbrek yetmezliği böbrekleriniz kanınızdaki atıkları yeterince filtreleme yeteneğini kaybettiğinde ortaya çıkar. Birçok faktör böbrek sağlığı ve işlevini etkiler, örneğin:
- çevresel kirleticilere veya bazı ilaçlara toksik derecede maruz kalma
- bazı akut ve kronik hastalıklar
- şiddetli dehidrasyon
- böbrek travması
Böbrekleriniz normal işlerini yapamıyorsa vücudunuz toksinlerle aşırı yüklenir. Bu böbrek yetmezliğine yol açabilir ve tedavi edilmezse hayati tehlike oluşturur.
Böbrek yetmezliğinin semptomları nelerdir?
Böbrek yetmezliği sırasında birçok farklı semptomlar ortaya çıkabilir. Genellikle böbrek yetmezliği olan bir kişi, bazen hiçbiri bulunmamasına rağmen, hastalığın birkaç belirtisine sahip olacaktır. Olası semptomlar şunları içerir:
- azaltılmış miktarda idrar
- bacaklarının, ayak bileklerinin ve ayakların şişmesi, böbreklerinin su israfını engellememesinden kaynaklanan sıvıların tutulmasından kaynaklanır
- açıklanamayan nefes darlığı
- aşırı uyuşukluk veya halsizlik
- kalıcı mide bulantısı
- karışıklık
- göğsünüzde ağrı veya basınç
- nöbetler
- koma
Böbrek yetmezliğine ne neden olur?
Böbrek yetmezliği için en fazla risk altında olan kişilerin genellikle aşağıdaki nedenlerden biri veya birkaçı vardır:
Böbreklere kan akışı kaybı
Böbreklerinize ani bir kan akışı kaybı böbrek yetmezliğine neden olabilir. Böbreklere kan akışı kaybına neden olan bazı hastalıklar ve durumlar şunlardır:
- kalp krizi
- kalp hastalığı
- karaciğerin skarlanması veya karaciğer yetmezliği
- kurutma
- ciddi bir yanık
- alerjik reaksiyon
- sepsis gibi ciddi bir enfeksiyon
Yüksek tansiyon ve iltihap önleyici ilaçlar da kan akışını sınırlayabilir.
İdrar eliminasyon sorunları
Vücudunuz idrarı elimine edemediğinde, toksinler birikir ve böbrekleri aşırı yükler. Bazı kanserler idrar yollarını tıkayabilir. Bunlar prostat (erkeklerde en sık görülen tip), kolon , servikal ve mesane kanserlerini içerir .
Diğer şartlar idrara çıkma ile etkileşime girebilir ve aşağıdakiler dahil muhtemelen böbrek yetmezliğine yol açabilir:
- böbrek taşı
- genişlemiş bir prostat
- idrar yolunuzdaki kan pıhtıları
- mesanenizi kontrol eden sinirlerin zarar görmesi
Diğer nedenler
Bazı hastalıklar ve durumlar, aşağıdakiler de dahil olmak üzere böbrek yetmezliğine yol açabilir:
- böbreklerinizin içinde veya çevresinde bir kan pıhtısı
- enfeksiyon
- ağır metallerden aşırı toksinlerin yüklenmesi
- uyuşturucu ve alkol
- vaskülit , kan damarlarının iltihabı
- lupus , birçok vücut organında iltihaplanmaya neden olabilen otoimmün bir hastalıktır
- glomerülonefrit , böbreklerin küçük kan damarlarının iltihabı
- genellikle bağırsaklardaki bakteriyel bir enfeksiyonun ardından kırmızı kan hücrelerinin parçalanmasını içeren hemolitik üremik sendrom
- multipl miyelom , kemik iliğinizde plazma hücrelerinin bir kanseri
- cildinizi etkileyen otoimmün bir hastalık olan skleroderma
- trombotik trombositopenik purpura , küçük damarlarda kan pıhtılaşmasına neden olan bir bozukluk
- kemoterapi ilaçları , kanseri tedavi eden ilaçlar ve bazı otoimmün hastalıklar
- bazı görüntüleme testlerinde kullanılan boyalar
- bazı antibiyotikler
- kontrolsüz diyabet
Beş çeşit böbrek yetmezliği
Beş farklı böbrek yetmezliği vardır:
Akut prerenal böbrek yetmezliği
Böbreklere yetersiz kan akışı, akut prerenal böbrek yetmezliğine neden olabilir. Böbrekler kandan yeterli miktarda kan akışı olmadan toksinleri süzemezler. Bu tür böbrek yetmezliği genellikle siz ve doktorunuz kan akışındaki azalmanın nedenini belirledikten sonra iyileştirilebilir.
Akut intrinsik böbrek yetmezliği
Akut içsel böbrek yetmezliği, fiziksel etki veya kaza gibi böbreklere doğrudan travma neden olabilir. Nedenleri ayrıca, toksin aşırı yükünü ve böbreklere oksijen eksikliği olan iskemidir. Aşağıdaki iskemiye neden olabilir:
- şiddetli kanama
- şok
- böbrek kan damarı tıkanıklığı
- glomerülonefrit
Kronik prerenal böbrek yetmezliği
Böbreklere uzun süre boyunca yeterli miktarda kan akmadığında, böbrekler küçülmeye ve işlevlerini kaybetmeye başlar.
Kronik içsel böbrek yetmezliği
Bu, gerçek böbrek hastalığına bağlı böbreklerde uzun süreli hasar olduğunda olur. İçsel böbrek hastalığına, ciddi kanama veya oksijen eksikliği gibi böbreklere doğrudan travma neden olur.
Kronik böbrek sonrası böbrek yetmezliği
Üriner sistemin uzun süreli tıkanması idrara çıkmayı önler. Bu, baskıya ve sonunda böbrek hasarına neden olur.
Böbrek yetmezliği nasıl teşhis edilir?
Doktorunuzun böbrek yetmezliğini teşhis etmek için kullanabileceği birkaç test vardır. Bunlar şunları içerir:
İdrar tahlili
Doktorunuz, idrarla dökülen anormal protein veya şeker dahil olmak üzere herhangi bir anormallik olup olmadığını test etmek için idrar örneği alabilir. Doktorunuz ayrıca idrar sediment muayenesi yapabilir. Bu, kırmızı ve beyaz kan hücrelerinin miktarını ölçer, yüksek düzeyde bakteri arar ve çok sayıda hücre atığı arar.
İdrar hacmi ölçümleri
İdrar çıkışını ölçmek, böbrek yetmezliğini teşhis etmeye yardımcı olan en basit testlerden biridir. Örneğin, düşük idrar çıkışı, böbrek hastalığının, çoklu hastalıklar veya yaralanmaların neden olabileceği idrar tıkanmasından kaynaklandığını ileri sürebilir.
Kan örnekleri
Doktorunuz, kan üre azotu (BUN) ve kreatinin (Cr) gibi böbrekleriniz tarafından filtrelenen maddeleri ölçmek için kan testleri isteyebilir. Bu seviyelerde hızlı bir artış, akut böbrek yetmezliğine işaret edebilir.
Görüntüleme
Ultrasonlar, MRG’ler ve BT taramaları gibi testler, böbreklerin kendilerini, idrar yollarıyla birlikte görüntüler. Bu, doktorunuzun böbreklerinizde tıkanmalar veya anormallikler aramasını sağlar.
Böbrek dokusu örneği
Doku örnekleri anormal birikintiler, yara izi ya da bulaşıcı organizmalar açısından incelenir. Doktorunuz doku örneğini toplamak için böbrek biyopsisi kullanacaktır. Biyopsi, genellikle uyanıkken yapılan basit bir işlemdir. Herhangi bir rahatsızlığı gidermek için yerel bir anesteziye sahip olacaksınız. Numune cildinizden ve böbreğinizden aşağıya sokulan bir biyopsi iğnesi ile toplanır. Röntgen veya ultrason cihazı böbrekleri yerleştirmek ve doktora iğneyi yönlendirmede yardımcı olmak için kullanılır.
Böbrek yetmezliği tedavisi
Böbrek yetmezliği için çeşitli tedaviler vardır. İhtiyacınız olan tedavi tipi böbrek yetmezliğinizin nedenine bağlı olacaktır. Doktorunuz, aşağıdakileri içerebilecek en iyi tedavi seçeneğini belirlemenize yardımcı olabilir:
Diyaliz
Diyaliz , bir makine kullanarak kanı filtreler ve temizler. Makine böbreklerin işlevini yerine getirir. Diyaliz tipine bağlı olarak, büyük bir makineye veya portatif kateter çantasına bağlı olabilirsiniz. Diyalizle birlikte düşük potasyumlu, düşük tuzlu diyeti takip etmeniz gerekebilir.
Diyaliz böbrek yetmezliğini tedavi etmez, ancak düzenli aralıklarla uygulanan tedavilere giderseniz hayatınızı uzatacaktır.
Böbrek nakli
Diğer bir tedavi seçeneği böbrek naklidir . Vücudunuzla uyumlu bir donör böbrek almak için genellikle uzun bir bekleme vardır, ancak yaşayan bir donörünüz varsa bu işlem daha hızlı ilerleyebilir.
Nakil işleminin avantajları, yeni böbreğin mükemmel çalışabilmesi ve diyaliz işlemine artık gerek kalmamasıdır. Dezavantajı, ameliyattan sonra immünosüpresif ilaçlar almanız gerektiğidir. Bu ilaçların, bazıları ciddi olan kendi yan etkileri vardır. Ayrıca, nakil ameliyatı her zaman başarılı değildir.
Böbrek yetmezliğini önleme
Böbrek yetmezliği riskinizi azaltmak için atabileceğiniz adımlar vardır.
Reçetesiz satılan ilaçları alırken talimatları izleyin. Çok yüksek dozlarda (aspirin gibi yaygın ilaçlardan bile) kısa sürede yüksek toksin seviyeleri oluşabilir. Bu, böbreklerinizi aşırı yükleyebilir.
Mümkün olduğunda, ev temizleyicileri, tütün ürünleri, böcek ilaçları ve diğer toksik ürünler gibi kimyasallara maruz kalma riskinizi azaltmalısınız.
Birçok böbrek veya idrar yolu koşulları, uygun şekilde tedavi edilmediklerinde böbrek yetmezliğine yol açar. Doktorunuzun tavsiyelerine uyun, her zaman belirtilen ilaçları alın ve sağlıklı bir yaşam tarzı sürdürün.
Kaynaklar:
Böbrek yetmezliği için bir tedavi seçimi. (Nd).
Diyabetik böbrek hastalığı. (2017).
Mayo Kliniği Kadrosu. (2015). Akut böbrek yetmezliği: Tanım.
Üroloji testleri ve prosedürleri: Böbrek biyopsisi. (Nd).